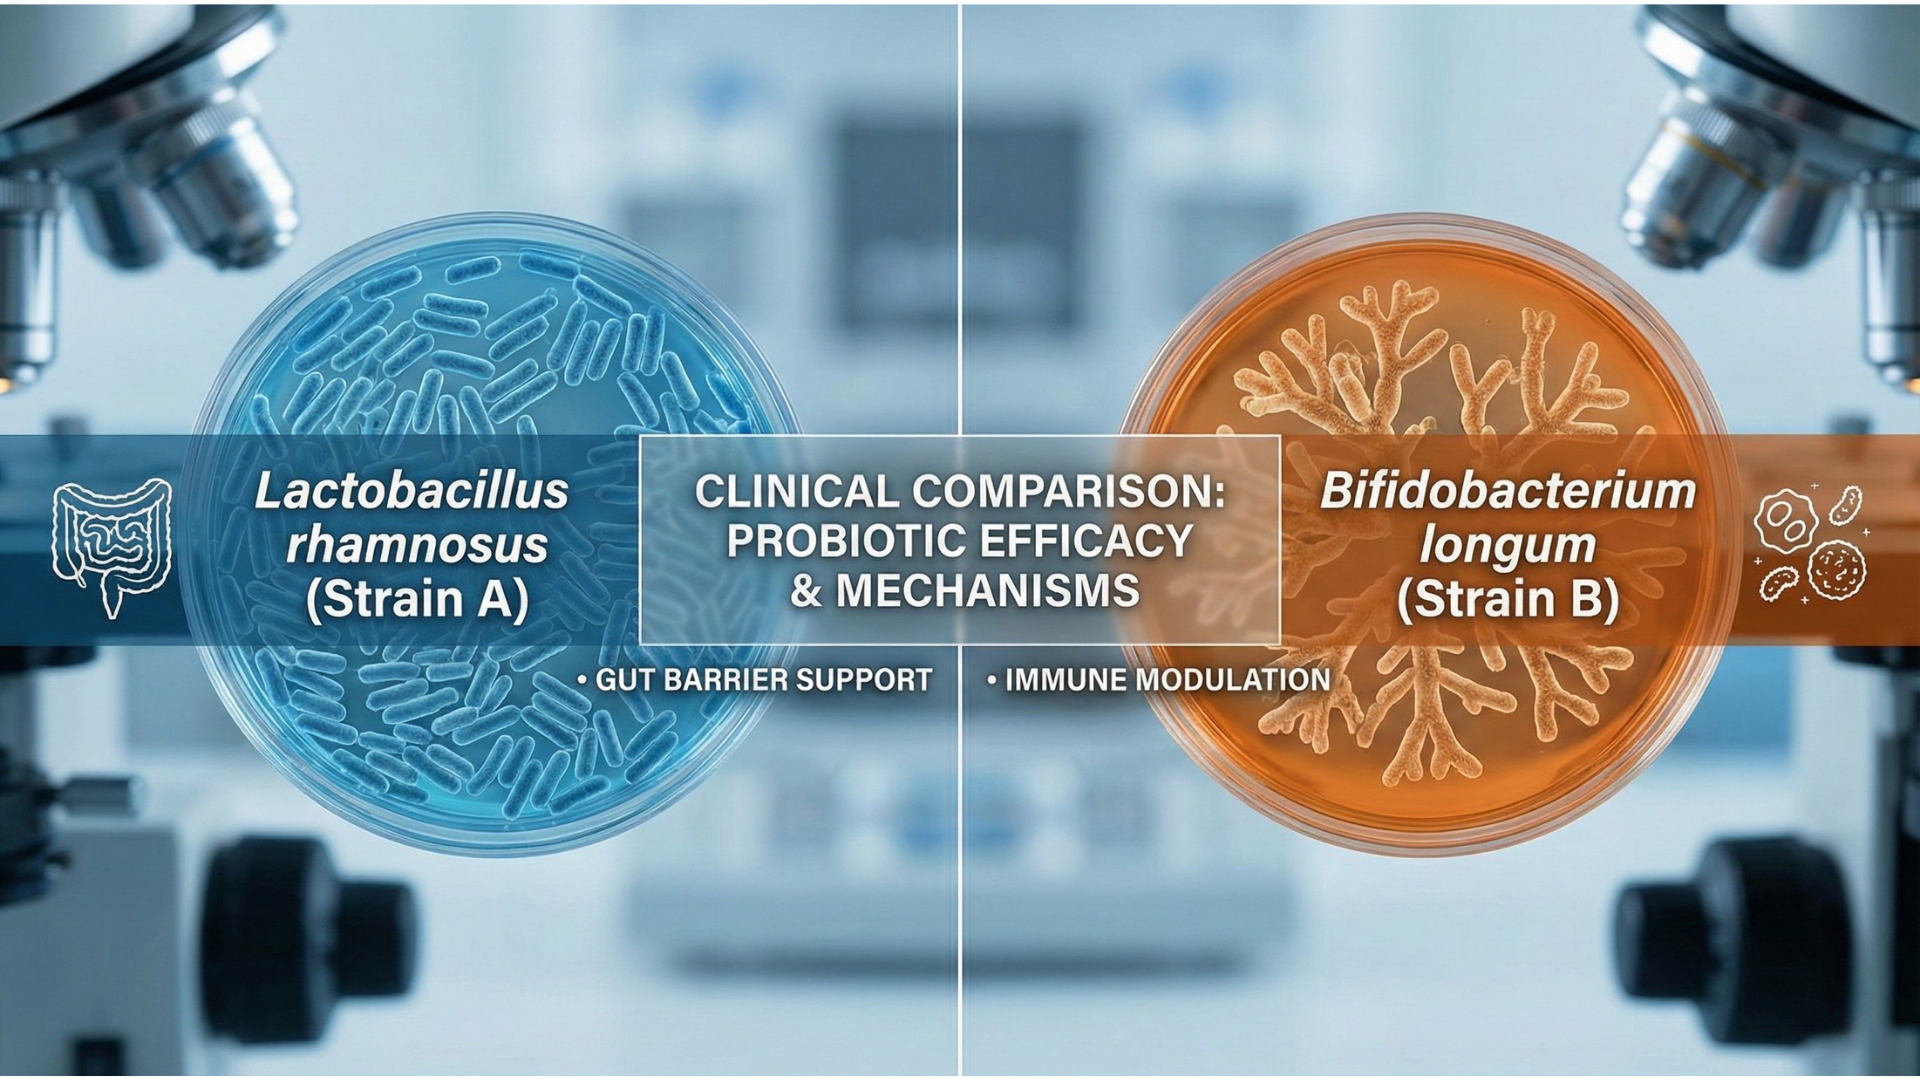
Clinical comparison of Lactobacillus rhamnosus and Bifidobacterium longum probiotic strains

The Complete Guide to Probiotic Supplement Manufacturing in 2026
Probiotic supplements require specialized manufacturing expertise to maintain live organism viability. This guide covers strains, CFU optimization, and manufacturing techniques for creating effective gut health products.

- 1Probiotic manufacturing requires climate-controlled facilities—most strains die above 104°F
- 2CFU overage is essential: reputable manufacturers add extra CFU to guarantee label claims at end of shelf life
- 3Spore-forming probiotics (Bacillus coagulans) survive manufacturing and digestion far better than vegetative strains
- 4Capsules offer the best viability-to-cost ratio; gummies are challenging but possible with spore-forming strains
- 5Verify your manufacturer tests CFU counts at multiple stages and guarantees potency through expiration
Manufacturing Living Products
Probiotic manufacturing is fundamentally different from other supplements. You're not just mixing ingredients—you're cultivating, protecting, and delivering live organisms that must survive production, packaging, storage, and digestion to provide benefits. Probiotics pair powerfully with prebiotic fiber supplements for complete gut health solutions.
This complexity creates both challenges and opportunities. Brands selling through Amazon FBA or Shopify that master probiotic manufacturing build products with real efficacy that generate loyal customers and positive reviews. Those that cut corners end up with ineffective products and damaged reputations.
Peakfinity Advantage
Peakfinity Labs operates climate-controlled probiotic manufacturing in our GMP-certified facilities with specialized equipment and quality controls. Our R&D team has formulated hundreds of probiotic products, from simple single-strain capsules to complex synbiotic blends.
The Gut Health Revolution
Consumer awareness of gut-health connections has exploded. Research linking the microbiome to immune function, mental health, skin condition, and metabolic health has driven the probiotic market past $50 billion globally.
- Immune Support: 70% of the immune system resides in the gut. Consumers now connect probiotics to overall wellness.
- Gut-Brain Axis: Research on mood, stress, and cognitive connections drives "psychobiotic" positioning.
- Gut-Skin Axis: Linking probiotics to clear skin resonates with beauty and wellness consumers.
- Digestive Comfort: Traditional IBS, bloating, and regularity benefits remain core messaging.
Probiotic Market Segments
| Segment | Key Positioning | Target Consumer | Growth Rate |
|---|---|---|---|
| General Digestive | Daily wellness | Health-conscious adults | +8% |
| Immune Support | Defense/protection | Parents, seniors | +12% |
| Women's Health | Vaginal/urinary balance | Women 25-50 | +15% |
| Mental Wellness | Mood/stress support | Stressed professionals | +18% |
| Kids | Fun formats | Parents of kids 4-12 | +10% |
Probiotic Strains & Benefits
Strain selection is crucial. Different probiotic strains offer different benefits, and "probiotic" is not a one-size-fits-all category.
Common Probiotic Strains and Benefits
| Strain | Benefits | Stability | CFU Range |
|---|---|---|---|
| Lactobacillus acidophilus | Digestive balance, immunity | Moderate | 1-10B |
| Bifidobacterium lactis | Immune support, regularity | Good | 1-50B |
| Lactobacillus rhamnosus GG | Diarrhea prevention, immunity | Moderate | 1-10B |
| Bacillus coagulans | Digestive comfort, stable | Excellent | 1-5B |
| Saccharomyces boulardii | Traveler's diarrhea, antibiotics | Excellent | 250-500M |
| Lactobacillus plantarum | Bloating, IBS symptoms | Good | 1-20B |
Spore-Forming vs Vegetative Strains: Spore-forming probiotics (like Bacillus coagulans) form protective shells that dramatically improve survival through manufacturing and digestion. Vegetative strains require more careful handling but offer broader diversity.
The Probiotic Manufacturing Process
Probiotic manufacturing requires specialized processes to maintain viability from cultivation through consumer use:
- Strain Cultivation: Probiotic strains are grown in controlled fermentation environments. Temperature, pH, and nutrients are precisely managed for optimal growth.
- Harvesting: Cells are separated from growth medium through centrifugation or filtration while maintaining viability.
- Concentration: Probiotic concentrates are prepared at high CFU counts to accommodate expected losses during processing and shelf life.
- Protective Processing: Freeze-drying (lyophilization) or other techniques stabilize cells for dry storage. This step is critical for shelf stability.
- Blending: Multiple strains and supportive ingredients (prebiotics, vitamins) are combined in climate-controlled environments.
- Encapsulation/Tableting: Products are encapsulated with minimal heat and moisture exposure. Enteric coating may be applied for stomach acid protection.
- Packaging: Moisture-barrier packaging with desiccants maintains low water activity. Nitrogen flushing removes oxygen.
Viability Challenges & Solutions

Keeping probiotics alive is the central manufacturing challenge. Multiple factors threaten viability:
- Heat Sensitivity: Most strains die above 104°F. Manufacturing, shipping, and storage must control temperature. Solution: cold chain logistics or heat-stable strains.
- Moisture Damage: Water reactivates cells prematurely, leading to death. Solution: desiccants, moisture-barrier packaging, controlled humidity production.
- Oxygen Exposure: Many strains are oxygen-sensitive. Solution: nitrogen flushing, oxygen-barrier packaging, antioxidants.
- Stomach Acid: Gastric acid destroys many probiotics before reaching the intestine. Solution: enteric coating, microencapsulation, acid-resistant strains.
- Competitive Inhibition: Some strains inhibit others. Solution: careful strain compatibility testing, segregated packaging for multi-strain products.
Important
CFU counts on labels represent what's added at manufacturing, not what reaches consumers. Reputable manufacturers add "overage" (extra CFU) to ensure label claims are met at end of shelf life. Ask potential manufacturers about their overage practices.
Probiotic Product Formats
Format selection impacts viability, consumer experience, and manufacturing costs:
Probiotic Format Comparison
| Format | Viability | Consumer Experience | Cost | Best For |
|---|---|---|---|---|
| Capsules | Excellent | Easy, no taste | Low | Standard probiotics |
| Powder/Sachets | Good | Mixable, customizable | Low | High-dose, kids |
| Tablets | Good | Convenient | Low | Chewables, sustained release |
| Gummies | Challenging | Great taste, fun | High | Kids, marketing appeal |
| Liquid | Poor | Easy to take | Medium | Short shelf life products |
| Refrigerated | Excellent | Premium perception | High | Therapeutic products |
For most brands, capsules offer the best balance of viability, cost, and consumer acceptance. Gummies require spore-forming strains and accept lower CFU delivery. Refrigerated products signal quality but complicate logistics. Learn more about choosing formats in our supplement formats guide.
Choosing a Probiotic Manufacturer
Probiotic manufacturing requires specialized capabilities. Evaluate potential partners on:
- Climate Control: Temperature and humidity-controlled production and storage areas are non-negotiable. Ask about specific conditions.
- Viability Testing: Do they test CFU counts at multiple points? Do they guarantee potency at end of shelf life?
- Strain Expertise: Have they worked with your target strains? Do they understand compatibility issues?
- Cold Chain Capability: For refrigerated products, can they handle cold storage and shipping?
- Quality Documentation: Can they provide COAs with viability testing? Do they have validated stability data?
Peakfinity Advantage
Peakfinity Labs maintains dedicated climate-controlled probiotic production with viability testing at manufacture and throughout stability studies. We work with both shelf-stable and refrigerated formulations and guarantee label claims at end of shelf life.
Frequently Asked Questions
What CFU count should my probiotic have?
Consumer products typically range from 1 billion to 100 billion CFU. For general wellness, 10-25 billion CFU is common. Therapeutic applications may require higher counts. Always consider what survives to point of consumption, not just what's manufactured.
Do probiotics need to be refrigerated?
Not always. Shelf-stable probiotics use strains and manufacturing techniques that maintain viability at room temperature. Refrigerated products may have higher initial CFU counts but require cold chain logistics.
What's the difference between probiotics and prebiotics?
Probiotics are live beneficial bacteria. Prebiotics are fibers that feed those bacteria. Many modern products combine both (called synbiotics) for comprehensive gut support.
How do you ensure probiotic viability during manufacturing?
Key factors include strain selection (hardy strains), moisture control, avoiding heat exposure, protective delivery technologies (enteric coating, microencapsulation), and proper storage conditions.
Can probiotics be made into gummies?
Challenging but possible. The heat and moisture in gummy production kills most strains. Spore-forming probiotics (Bacillus coagulans) survive better. Even then, CFU delivery is lower than capsules.
What certifications matter for probiotic manufacturing?
FDA registration and cGMP are essential. Look for manufacturers with cold storage capabilities, climate-controlled production areas, and third-party viability testing at end of shelf life.

Tushar
Prior Pharmacist
Written by the Peakfinity Labs R&D Team — 46+ years of supplement formulation expertise. Our team of formulation chemists, manufacturing specialists, and regulatory experts has helped thousands of eCommerce brands bring their products to market successfully since 1980.
Related Articles

The Complete Guide to Collagen Supplement Manufacturing
Everything brands need to know about manufacturing collagen supplements, from types and formats to quality standards.

Gummy Vitamin Manufacturing Guide
Deep dive into gummy supplement manufacturing from formulation to production processes.

Peptide Supplement Manufacturing Guide
Manufacturing considerations for collagen peptides and bioactive peptide supplements.